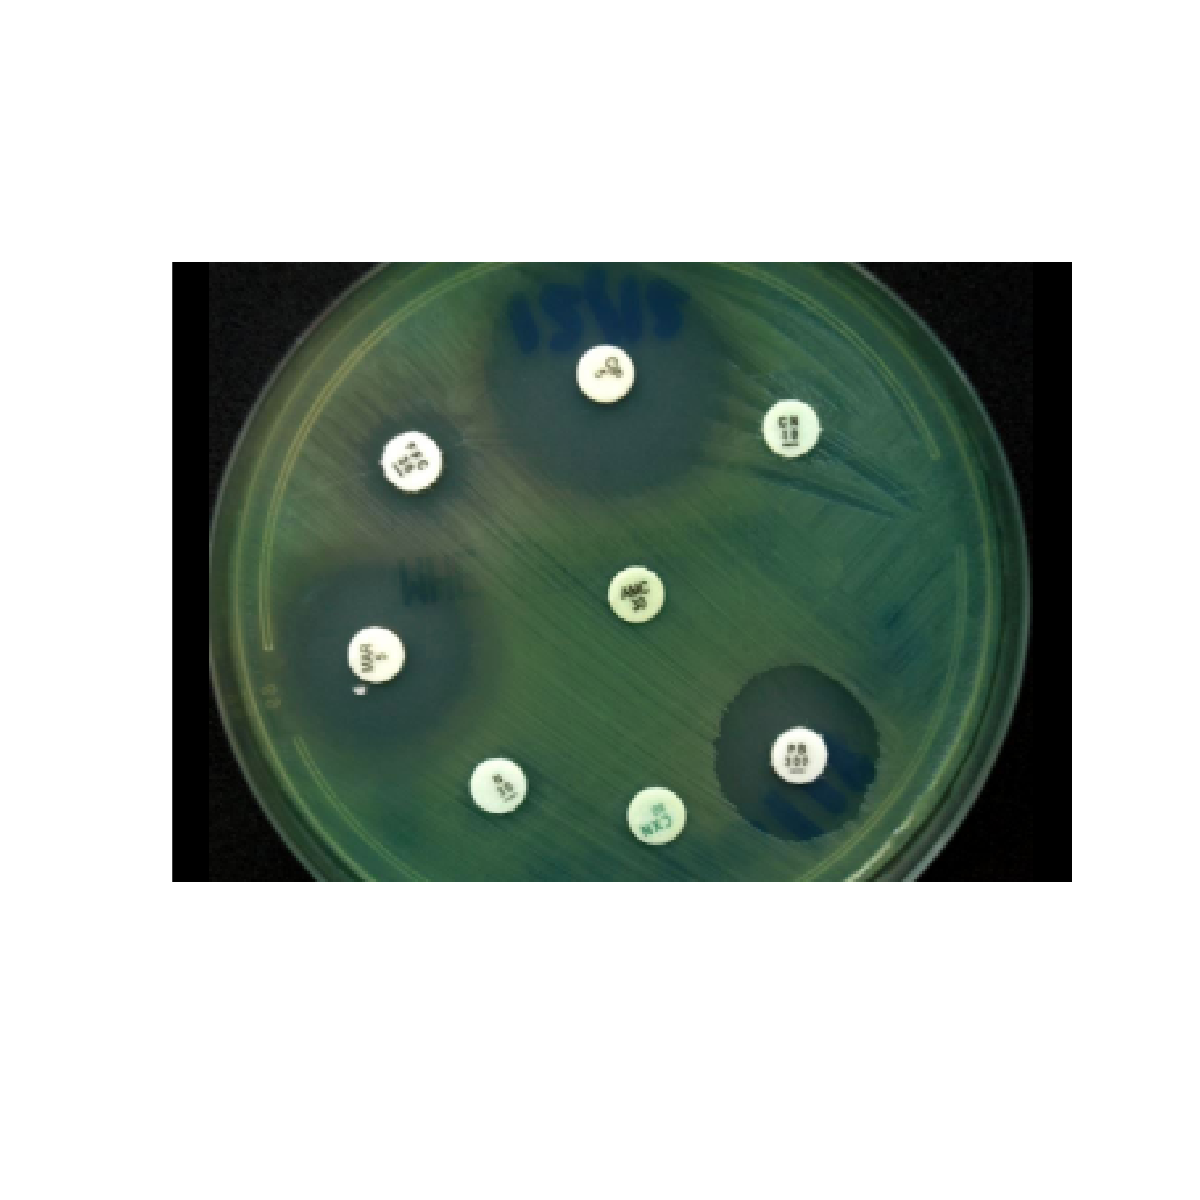
Oxoid™ Vancomycin Antimicrobial Susceptibility discs / Discos de susceptibilidad antimicrobiana a la vancomicina Oxoid™

En Stock
Oxoid™ Vancomycin Antimicrobial Susceptibility discs / Discos de susceptibilidad antimicrobiana a la vancomicina Oxoid™
[SKU: CT0058B]
Determine manualmente la susceptibilidad a los antibióticos de los microorganismos utilizando métodos de prueba de susceptibilidad a los antimicrobianos (AST) junto con discos de susceptibilidad a los antimicrobianos Thermo Scientific™ Oxoid™ confiables y fáciles de usar.
S/ 0.00
Oxoid™ Vancomycin Antimicrobial Susceptibility discs / Discos de susceptibilidad antimicrobiana a la vancomicina Oxoid™
Determine manualmente la susceptibilidad a los antibióticos de los microorganismos utilizando métodos de prueba de susceptibilidad a los antimicrobianos (AST) junto con discos de susceptibilidad a los antimicrobianos Thermo Scientific™ Oxoid™ confiables y fáciles de usar.